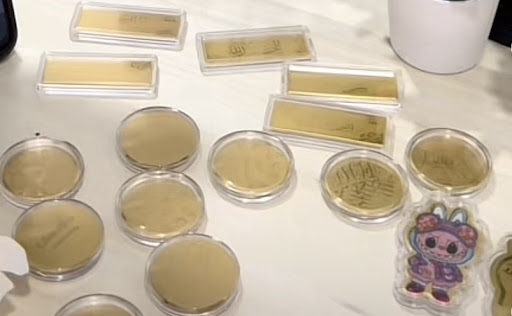
Kedai Emas Pioneer

Kedai Emas Pioneer

Di Johor Bahru, terdapat sebuah kedai emas yang semakin menonjol dalam industri perhiasan Malaya, iaitu Kedai Emas Pioneer. Dikenali dengan reka bentuk unik dan kualiti tinggi, kedai ini menjadi tumpuan ramai pembeli yang mencari barang kemas yang elegan dan berpatutan. Artikel ini akan membincangkan peranan Kedai Emas Pioneer dalam memajukan industri perhiasan di Malaysia serta daya tarikannya yang tersendiri dalam kalangan masyarakat tempatan.
1st Floor, Tasek Central, Lot 1-01, No. 2, Jalan Pendekar 16, Taman Ungku Tun Aminah, 81300 Skudai, Johor, Malaysia
+60 7-558 3163
5/5 (Baca Ulasan)
Kedai Emas Pioneer, yang terletak di 1st Floor, Tasek Central, Lot 1-01, No. 2, Jalan Pendekar 16, Taman Ungku Tun Aminah, 81300 Skudai, Johor, Malaysia, merupakan pilihan terbaik bagi pelanggan yang mencari kualiti dan kepercayaan dalam pembelian emas. Dengan pelbagai pilihan produk dan reka bentuk yang eksklusif, Kedai Emas Pioneer menawarkan pengalaman membeli-belah yang selesa dan memuaskan. Pelanggan juga boleh menghubungi mereka melalui nombor telefon +60 7-558 3163 untuk sebarang pertanyaan atau maklumat lanjut.
Maklumat lanjut
Di manakah lokasi Kedai Emas Pioneer?
Kedai Emas Pioneer terletak di 1st Floor, Tasek Central, Lot 1-01, No. 2, Jalan Pendekar 16, Taman Ungku Tun Aminah, 81300 Skudai, Johor, Malaysia. Kedai ini berada di kawasan strategik yang mudah diakses oleh pelanggan dari pelbagai tempat di sekitar Johor.
Berapakah nombor telefon untuk menghubungi Kedai Emas Pioneer?
Nombor telefon untuk menghubungi Kedai Emas Pioneer ialah +60 7-558 3163. Pelanggan boleh menghubungi nombor ini untuk sebarang pertanyaan mengenai produk emas, promosi, atau jadual perkhidmatan yang disediakan.
Apakah jenis perkhidmatan yang ditawarkan oleh Kedai Emas Pioneer?
Kedai Emas Pioneer menawarkan pelbagai perkhidmatan termasuk jualan emas, perak, dan barang kemas berkualiti tinggi. Mereka juga menawarkan perkhidmatan pembelian emas terpakai serta servis penyelenggaraan dan pembaikan barang kemas untuk memastikan pelanggan mendapat nilai yang terbaik.
Berapa tahun pengalaman Kedai Emas Pioneer dalam industri emas?
Kedai Emas Pioneer mempunyai pengalaman lebih daripada 5 tahun dalam industri emas di Malaysia. Pengalaman yang luas ini membolehkan mereka memberi perkhidmatan yang berkualiti dan pengetahuan yang mendalam tentang pasaran emas kepada pelanggan mereka.

